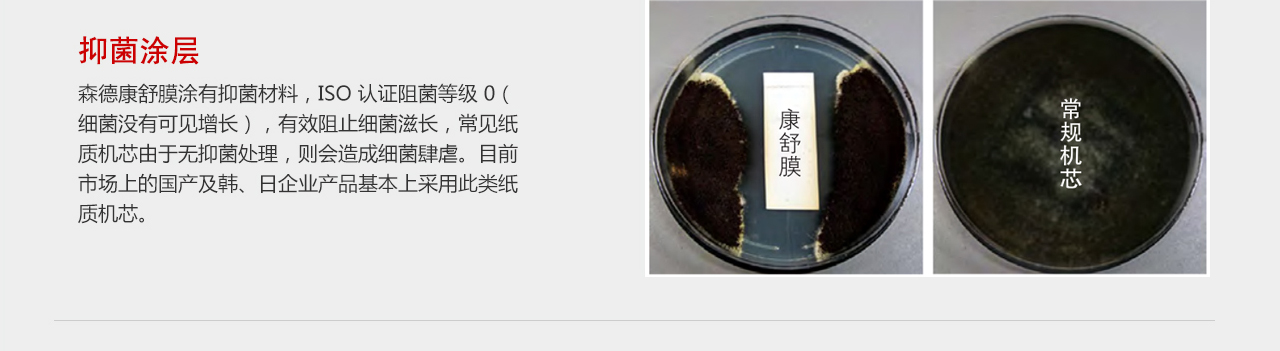
森德康舒膜熱交換機(jī)芯-森德官方網(wǎng)站

|
|
|
| <track id="gdyh8"><label id="gdyh8"><th id="gdyh8"></th></label></track><bdo id="gdyh8"><span id="gdyh8"><del id="gdyh8"></del></span></bdo>